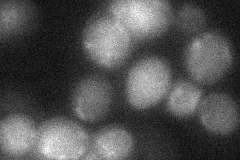
YMR036C
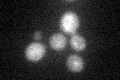
YMR036C

View description
Protein tyrosine phosphatase involved in cell cycle control; regulates the phosphorylation state of Cdc28p; homolog of S. pombe cdc25
Localization:
Intensity:
Fold change:
Significance:
-
C’ GFP library in SD

below threshold16.39 -
N' NOP1pr-GFP in SD

below threshold0 -
N' TEF2pr-mCherry in SD

nucleus14.4771 -
N' NATIVEpr-GFP in SD

below threshold21.0581 -
N' TEF2pr-VC and Cyto-VN in SD
below threshold27.6949 -
C’ GFP library in SD+DTT
cytosol15.990.97No -
C’ GFP library in SD+H2O2

cytosol17.431.06No -
C’ GFP library in Starvation Media

cytosol15.40.93No -
C’ GFP library on the background of Pup2-DaMP

below threshold -
C’ GFP library on the background of CCT mutant

below threshold17.02651.03858No
